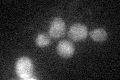
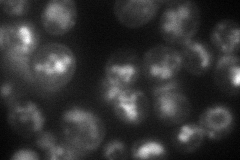
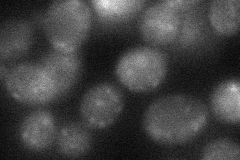
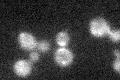

View description
Chitin synthase I, requires activation from zymogenic form in order to catalyze the transfer of N-acetylglucosamine (GlcNAc) to chitin; required for repairing the chitin septum during cytokinesis; transcription activated by mating factor
Localization:
Intensity:
Fold change:
Significance:
-
C’ GFP library in SD
below threshold19.68 -
N' NOP1pr-GFP in SD

punctate,bud49.0123 -
N' TEF2pr-mCherry in SD
cell periphery,vacuole58.668 -
N' NATIVEpr-GFP in SD

punctate,bud35.1289 -
N' TEF2pr-VC and Cyto-VN in SD
punctate33.3331 -
C’ GFP library in SD+DTT

cytosol28.511.44No -
C’ GFP library in SD+H2O2
cytosol19.891.01No -
C’ GFP library in Starvation Media

cytosol25.181.27No -
C’ GFP library on the background of Pup2-DaMP

below threshold -
C’ GFP library on the background of CCT mutant

below threshold16.36730.831373No
